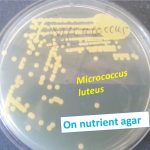
Nutrient agar
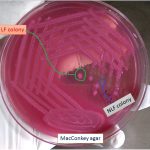
MacConkey agar
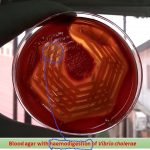
Blood agar with haemodigestion

Collection Group: Clinical Bacteriology
Nutrient agar: Introduction, Composition, Preparation, Test Procedure, Colony Characteristics and Uses
Nutrient agar with Micrococcus luteus Nutrient agar is a simple...
Nutrient agar with Micrococcus luteus Nutrient agar is a simple...
MacConkey agar with Lactose fermenter (LF) and Non Lactose Fermenter (NLF) colony
MacConkey agar MacConkey agar uses for culture of gram negative...
MacConkey agar MacConkey agar uses for culture of gram negative...
Blood agar with haemodigestion:Introduction and differences between haemodigestion and haemolysis
Haemodgestion in blood agar Haemodigestion of blood agar showing clear zone...
Haemodgestion in blood agar Haemodigestion of blood agar showing clear zone...
